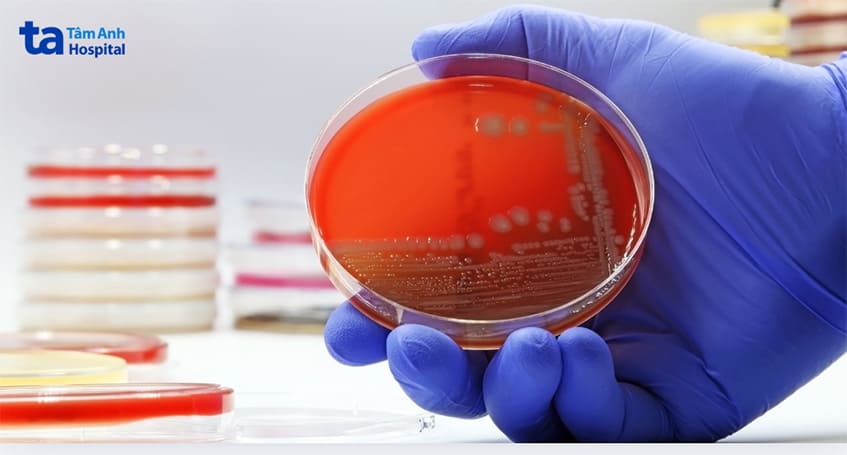
Viêm bàng quang nhẹ do E.coli gây ra có thể tự khỏi

Viêm bàng quang là tình trạng nhiễm trùng bàng quang do vi khuẩn xâm nhập. Vì có nguyên nhân do vi khuẩn, nên nhiều người không khỏi lo lắng, liệu viêm bàng quang có lây không? Nếu có thì lây qua đường nào? Bài viết dưới đây, bác sĩ CKI Nguyễn Cao Tháp, khoa Tiết niệu, Trung tâm Tiết niệu – Thận học – Nam khoa, BVĐK Tâm Anh TP.HCM sẽ tư vấn giải đáp thắc mắc.

Viêm bàng quang không lây từ người này qua người khác, kể cả khi nguyên nhân gây bệnh là do vi khuẩn hoặc có quan hệ tình dục không an toàn với người bệnh. Tuy nhiên, hoạt động tình dục có thể làm tăng nguy cơ nhiễm bệnh vì nó có thể đẩy vi khuẩn bên ngoài vào niệu đạo, tấn công bàng quang. Đây là lý do vì sao các bác sĩ khuyến cáo nên đi tiểu sau quan hệ tình dục để loại bỏ vi khuẩn có thể đã xâm nhập vào đường tiết niệu.
Vi khuẩn phổ biến nhất gây nhiễm trùng đường tiết niệu là Escherichia coli (E. coli), thường được tìm thấy trong đường tiêu hóa và ruột. Trong điều kiện bình thường, nó vô hại. Tuy nhiên, E. coli phát triển mạnh trong môi trường axit của bàng quang gây ra viêm bàng quang. (1)
Nếu không được điều trị, nhiễm trùng có thể tấn công sâu hơn vào hệ tiết niệu, gây viêm nhiễm toàn bộ hệ thống, từ niệu đạo, bàng quang, niệxu quản và cuối cùng là thận. Viêm bể thận là tình trạng nghiêm trọng vì nó gây tổn thương thận hoặc thậm chí là suy thận.
Phụ nữ ở độ tuổi thanh thiếu niên dễ bị viêm bàng quang, đặc biệt nếu họ có hoạt động tình dục. Niệu đạo ở nữ có chiều dài khoảng 4cm, nằm gần âm đạo và hậu môn nên niệu đạo nữ dễ bị vi khuẩn xâm nhập, điều này góp phần làm tăng nguy cơ nhiễm trùng đường tiết niệu.
Những thời điểm khiến phụ nữ dễ bị nhiễm trùng hơn bao gồm:
Nam giới có xu hướng bị viêm bàng quang nhiều hơn trong giai đoạn trung niên và cao tuổi, thường do các vấn đề liên quan đến tuyến tiền liệt. Tăng sinh tuyến tiền liệt hoặc viêm tuyến tiền liệt có thể gây cản trở dòng nước tiểu, làm tăng khả năng ứ đọng vi khuẩn trong bàng quang và dẫn đến nhiễm trùng. Việc dòng nước tiểu không thông suốt là 1 trong những dấu hiệu cảnh báo, giúp chỉ ra nguy cơ nhiễm trùng có liên quan đến tuyến tiền liệt.
Ngoài ra, người lớn tuổi có hệ miễn dịch yếu có nguy cơ nhiễm trùng cao hơn, bao gồm viêm bàng quang. Các yếu tố khác như ống thông bàng quang và các phẫu thuật liên quan đến hệ tiết niệu cũng góp phần làm tăng nguy cơ nhiễm trùng đường tiết niệu, vì chúng tạo ra các lối vào tiềm ẩn cho vi khuẩn.
Việc chẩn đoán và điều trị viêm bàng quang ở nam giới cần thận trọng và thường dùng kháng sinh để điều trị. Nếu có các yếu tố phức tạp như tắc nghẽn do tuyến phình đại tiền liệt, người bệnh có thể cần thêm các biện pháp can thiệp để khôi phục dòng chảy nước tiểu bình thường.
Xem thêm: Viêm bàng quang khám ở khoa nào?

Viêm bàng quang không lây từ người này sang người khác qua bất kỳ con đường nào, kể cả qua quan hệ tình dục. E. coli là nguyên nhân chính gây viêm bàng quang, vi khuẩn này vốn tồn tại tự nhiên trong đường ruột và vùng hậu môn, thường sống hòa bình trong môi trường đó.
Tuy nhiên, khi môi trường sống mất cân bằng vi khuẩn, E. coli có thể phát triển mạnh và xâm nhập vào đường tiết niệu qua niệu đạo, đặc biệt dễ xảy ra ở phụ nữ do niệu đạo ngắn hơn. Khi E. coli tiếp cận bàng quang, môi trường thuận lợi bên trong bàng quang có thể khiến vi khuẩn nhân lên nhanh chóng, gây viêm niêm mạc bàng quang.
Một số bệnh lây qua đường tình dục (STIs), như lậu hoặc chlamydia, có thể dẫn đến viêm nhiễm ở đường tiết niệu, nhưng viêm bàng quang không phải là kết quả trực tiếp của các bệnh này mà là hậu quả gián tiếp khi hệ miễn dịch yếu hoặc có các tổn thương trong đường tiết niệu. Điều này có nghĩa là, mặc dù viêm bàng quang có thể xảy ra đồng thời với một số STIs, nhưng nó không được xem là 1 bệnh lây qua đường tình dục.
Việc vệ sinh cá nhân, đặc biệt là vệ sinh sau khi đi vệ sinh và quan hệ tình dục, uống nhiều nước và tránh nhịn tiểu trong thời gian dài là các biện pháp phòng ngừa viêm bàng quang.
Cách nhận biết tình trạng viêm bàng quang chủ yếu dựa vào các triệu chứng của bệnh. Đau khi đi tiểu là dấu hiệu nhận biết đầu tiên.
Các triệu chứng viêm bàng quang ở phụ nữ bao gồm: (2)

Nam giới có thể có triệu chứng viêm bàng quang tương tự như ở nữ, bao gồm:
Viêm bàng quang đôi khi có thể tự khỏi, đặc biệt khi nhiễm trùng nhẹ và giới hạn trong bàng quang mà chưa lan sang các bộ phận khác của hệ tiết niệu. Tuy nhiên, phần lớn các trường hợp cần dùng kháng sinh để loại bỏ hoàn toàn vi khuẩn gây bệnh, đặc biệt là E. coli – nguyên nhân gây viêm bàng quang ở khoảng 95% các trường hợp.
Các dạng viêm bàng quang không do vi khuẩn, như viêm bàng quang kẽ (viêm bàng quang mạn tính), viêm do hóa chất hoặc phóng xạ, hoặc viêm do các tác nhân vật lý, thường không tự khỏi và cần điều trị y tế ngay để ngăn ngừa biến chứng lâu dài.
Việc nhận biết các triệu chứng kịp thời và điều trị sớm giúp ngăn ngừa biến chứng nghiêm trọng, như viêm bể thận, đồng thời làm giảm thời gian và mức độ nghiêm trọng của bệnh.
Viêm bàng quang có thể di truyền. Tuy nhiên, viêm bàng quang thông thường không phải là 1 bệnh di truyền trực tiếp. Tuy nhiên, một số nghiên cứu cho thấy rằng viêm bàng quang mạn tính, hay còn gọi là viêm bàng quang kẽ (IC) hoặc hội chứng đau bàng quang (BPS), có thể có yếu tố di truyền trong gia đình.
Nghiên cứu về các cặp song sinh và tiền sử gia đình cho thấy một số người có thể có khuynh hướng di truyền đối với tình trạng này, nhưng nguyên nhân chính xác và cơ chế di truyền của viêm bàng quang kẽ vẫn chưa rõ ràng và cần thêm nghiên cứu.
Đến nay, bằng chứng khoa học chưa đủ để khẳng định viêm bàng quang có di truyền không? hoặc nếu có, di truyền theo cơ chế nào?
Khi có triệu chứng viêm bàng quang, nên đi khám bác sĩ để được đánh giá đúng tình trạng và có phương án điều trị phù hợp. Việc tự mua thuốc mà không có chỉ định của bác sĩ có thể khiến tình trạng nặng hơn và tăng nguy cơ biến chứng. Các biện pháp hỗ trợ điều trị viêm bàng quang bao gồm:
Những biện pháp này giúp kiểm soát triệu chứng và hạn chế nguy cơ viêm bàng quang tái phát hoặc biến chứng.
Việc điều trị viêm bàng quang đúng cách giúp ngăn ngừa các biến chứng và đẩy nhanh quá trình phục hồi. Dưới đây là một số lưu ý quan trọng:
Trong quá trình điều trị viêm bàng quang, vệ sinh đúng cách và tránh quan hệ tình dục trong thời gian mắc bệnh là biện pháp quan trọng để giảm nguy cơ tái phát và đảm bảo hiệu quả điều trị.
Chẩn đoán và điều trị sớm viêm bàng quang giúp hạn chế các tổn thương tiềm ẩn cho hệ tiết niệu do nhiễm trùng gây ra, bảo vệ hệ tiết niệu khỏi các nguy cơ bị tổn thương do biến chứng của viêm bàng quang.
Chữa viêm bàng quang tại khoa Tiết niệu, Trung tâm Tiết niệu – Thận học – Nam khoa, BVĐK Tâm Anh TP.HCM và Đơn vị Tiết niệu, Trung tâm khám chữa bệnh Tâm Anh Quận 7. Tại đây, quy tụ đội ngũ bác sĩ giỏi, giàu kinh nghiệm, kết hợp cùng hệ thống trang thiết bị y tế hiện đại, cơ sở vật chất khang trang, phục vụ công tác khám chữa bệnh chất lượng cao.
Chẩn đoán chính xác và phác đồ điều trị cá thể hóa, phù hợp với từng tình trạng cụ thể của từng người, sẽ giúp người bệnh nhanh chóng đẩy lùi viêm bàng quang và kiểm soát các đợt viêm đường tiết niệu bùng phát trong tương lai.
HỆ THỐNG BỆNH VIỆN ĐA KHOA TÂM ANH
Hy vọng với các thông tin bài viết vừa chia sẻ, đã giúp giải đáp thắc mắc về việc viêm bàng quang có lây không? lây qua đường nào? Dù không lây nhiễm, nhưng bác sĩ Tiết niệu vẫn nhấn mạnh người bệnh viêm bàng quang nên giữ vệ sinh vùng sinh dục đúng cách, tránh quan hệ tình dục để quá trình hồi phục diễn ra thuận lợi.